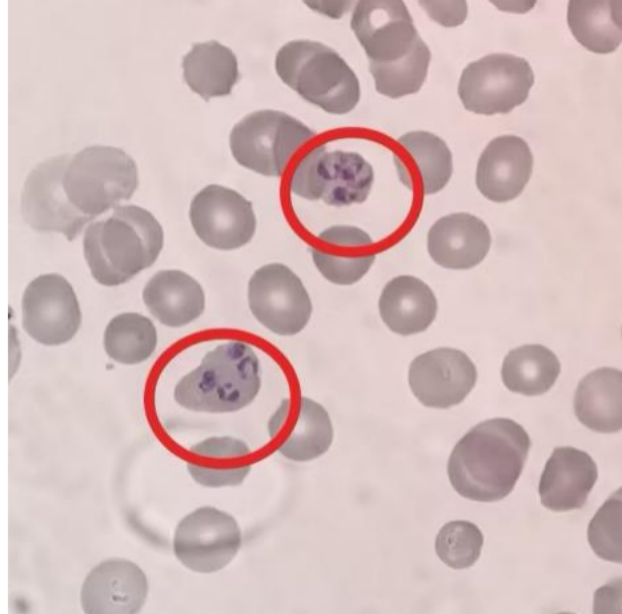

提到疟疾,很多人觉得它离我们很遥远。广西在2019年通过了国家消除疟疾考核,自2013年起连续13年没有出现本地感染病例。然而,随着跨境人员流动增多,输入性疟疾的风险反而增加。更关键的是,广西境内能传播疟疾的按蚊仍广泛存在,这使得“防止疟疾输入再传播”的防控任务变得十分艰巨。在感染人类的五种疟原虫中,恶性疟原虫与间日疟原虫是最具危害性的两种,分别引起恶性疟和间日疟。它们在危害等级、临床表现和复发特性等方面有所不同。目前全球疟疾的流行形势依然严峻,2024年全球约有2.82亿疟疾病例,导致61万人死亡,主要集中在非洲和东南亚地区。广西的输入性病例多来自这些地区,跨境务工、经商和留学人员是高发人群。

感染疟疾后,患者会出现周期性发冷、发热和大量出汗等症状。如果误诊或延误治疗,可能发展为重症,甚至危及生命。尽管疟疾凶险,但只要做好防护并及时治疗,它是完全可以预防和治愈的。结合广西按蚊的习性,这份通俗易懂的防疟指南对大家来说非常重要。

今年4月26日是第19个全国疟疾日,主题是“防疟疾、防输入、早发现、早诊疗”。提醒大家,消除疟疾不是终点,而是常态化防控的新起点。要警惕疟疾输入风险,做好个人防护,整治周边环境,共同守护自己和家人的健康,筑牢广西疟疾防控防线。